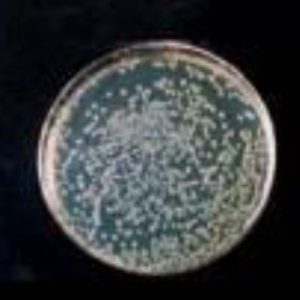
כמות החיידקים ללא ציפוי

Anti.BAC® – הציפוי האנטי-בקטריאלי של SIMEON
סטנדרט חדש בהיגיינה לחדרי ניתוח
היגיינה בחדרי ניתוח ובחדרי טיפולים חשובה כיום יותר מאי פעם. הדרישות בתחום זה הולכות ומחמירות, וכל פתרון המסייע לשמור על סביבה סטרילית ובטוחה הוא בעל ערך קריטי עבור בתי חולים ומרפאות.
למרות השיפור המתמיד באמצעי הניקיון והחיטוי, התפשטות זיהומים בחדרי ניתוח וטיפולים נמצאת במגמת עלייה. העברת חיידקים אינה מתרחשת רק במגע ישיר בין בני אדם, אלא גם – ולעיתים בעיקר – באמצעות מגע עקיף דרך משטחים, ציוד ומכשור הנמצאים בשימוש יומיומי בחדרי ניתוח.
לכן, כל רכיב בסביבת העבודה הכירורגית חייב לעמוד בסטנדרטים הגבוהים ביותר של היגיינה וניקיון – ובכלל זה גם מערכות התאורה, שהן מרכיב חיוני להצלחת כל פרוצדורה רפואית.
SIMEON Medical – תאורה חכמה עם הגנה אנטי-בקטריאלית מובנית
היצרן הגרמני SIMEON Medical תומך בבתי חולים ברחבי העולם באמצעות שילוב של ציפוי אנטי-בקטריאלי מתקדם בכל מערכות התאורה שלו, המפחית את כמות החיידקים על פני השטח ב־99.99%.
בשילוב עם:
איכות תאורה יוצאת דופן
שדה הארה אחיד והומוגני
ועיצוב מוקפד לשימוש קל ובטוח
מנורות הניתוח והטיפולים של SIMEON מהוות פתרון ייחודי, מתקדם ובטיחותי לסביבות רפואיות קריטיות.
מבנה סגור, חומרים איכותיים וניקוי קל
מערכות התאורה של SIMEON Medical מתאפיינות:
במבנה סגור והרמטי
בשימוש בלעדי בחומרים איכותיים כמו אלומיניום וזכוכית אמיתית
ובהיעדר חריצים ואזורים מועדים להצטברות לכלוך
כתוצאה מכך, ניתן לנקות ולחטא את המנורות בקלות ובבטחה באמצעות כל חומרי החיטוי הרפואיים המקובלים.
Anti.BAC® – ציפוי אנטי-מיקרוביאלי מתקדם
הציפוי Anti.BAC® הוא:
ציפוי אבקה אנטי-מיקרוביאלי ייעודי
העומד בתקן ISO 22196 (JIS Z 2801)
ומהווה סימן מסחרי רשום של SIMEON
כל רכיבי מערכות התאורה מצופים בשכבת ההגנה הזו, כולל:
ראשי התאורה
זרועות
כיסויים
ידיות
וכל חלק חיצוני שבא במגע עם הצוות הרפואי
כך, כל מערכת התאורה כולה תורמת באופן פעיל לשיפור רמת ההיגיינה בחדרי הניתוח והטיפולים.
המנורות מסופקות ללקוח כבר מהמפעל עם הציפוי, אשר מפחית באופן דרמטי את כמות החיידקים על פני השטח בשיעור של 99.99%.
יעילות מוכחת – ללא כסף וללא סיכונים פיזיולוגיים
ל־Anti.BAC® יש השפעה אנטי-מיקרוביאלית גבוהה במיוחד:
Log 5.9 נגד Escherichia coli
Log 4.29 נגד Staphylococcus aureus
ובכך הוא משיג הפחתה של 99.99% מכמות החיידקים.
חשוב לא פחות:
הציפוי אינו משתמש בננו-כסף או ביוני כסף חופשיים, הידועים כבעלי פוטנציאל לסיכונים פיזיולוגיים. בכך הפכה SIMEON ליצרן הראשון בתחום שמבטל לחלוטין את השימוש ביוני כסף בציפויים האנטי-בקטריאליים שלו.
התוצאה:
ציפוי בטוח, מתקדם ויעיל, המונע מחיידקים להתיישב על מערכות התאורה ותורם תרומה משמעותית להיגיינה בחדר הניתוח.

my.GRIP – שליטה מלאה, בסטריליות מלאה
יתרון משמעותי נוסף של מנורות הניתוח של SIMEON הוא קונספט ההפעלה האינטואיטיבי my.GRIP, המשולב בידית הסטרילית של ראשי התאורה.
באמצעות my.GRIP:
המנתח יכול לבצע את כל פעולות השליטה במנורה ביד אחת בלבד
וכל זאת מתוך השדה הסטרילי, ללא צורך בעזרת צוות נוסף
באמצעות תנועות סיבוביות קצרות או ארוכות על הידית הסטרילית, ניתן:
לשנות את עוצמת התאורה
להתאים את קוטר שדה התאורה
ולשלוט בפונקציות נוספות של המנורה
המערכת מאפשרת עד 12 שילובי הגדרות אישיים, כך שכל מנתח יכול להתאים את התאורה בדיוק לצרכיו.
תאורה ללא צללים – גם בתנאים קיצוניים
בנוסף לתכונות ההיגייניות המתקדמות, טכנולוגיית הרפלקטור הייחודית של SIMEON (המוגנת בפטנט) מאפשרת:
הארת שדה הניתוח ללא הצללה
גם כאשר אנשי הצוות חוסמים כמעט לחלוטין את האור באזור ראש התאורה
התוצאה:
שדה ניתוח מואר באופן אחיד, ברור ובטוח – גם בתנאים המורכבים ביותר.
לסיכום
מנורות הניתוח והטיפולים של SIMEON Medical משלבות:
תאורה מתקדמת ברמה הגבוהה ביותר
ציפוי אנטי-בקטריאלי פעיל Anti.BAC®
עיצוב חכם ונוח לשימוש
ותרומה אמיתית לשיפור ההיגיינה ובטיחות המטופלים
🔗 למידע נוסף על מנורות SIMEON:
https://medisale.org/surgical-lights/
